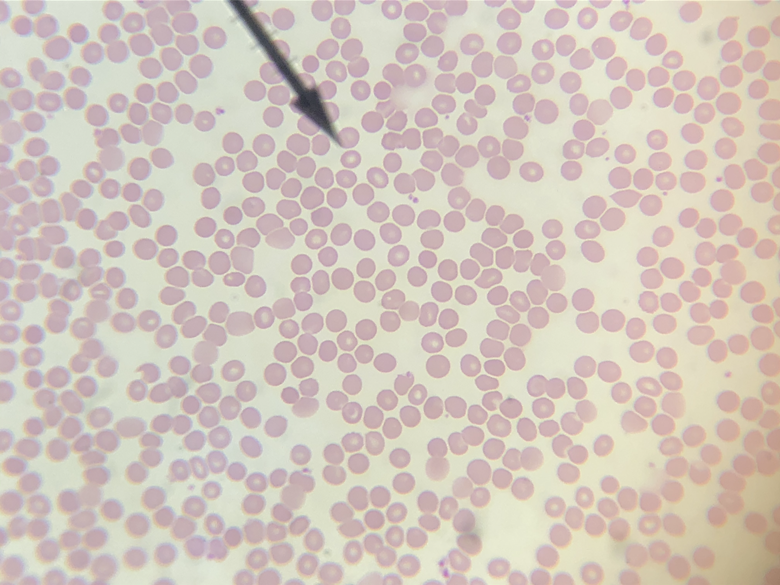
term image
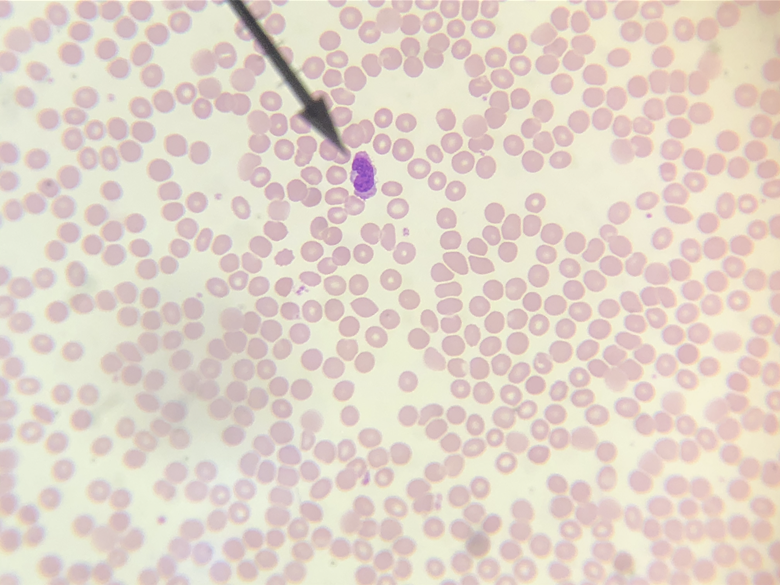
term image
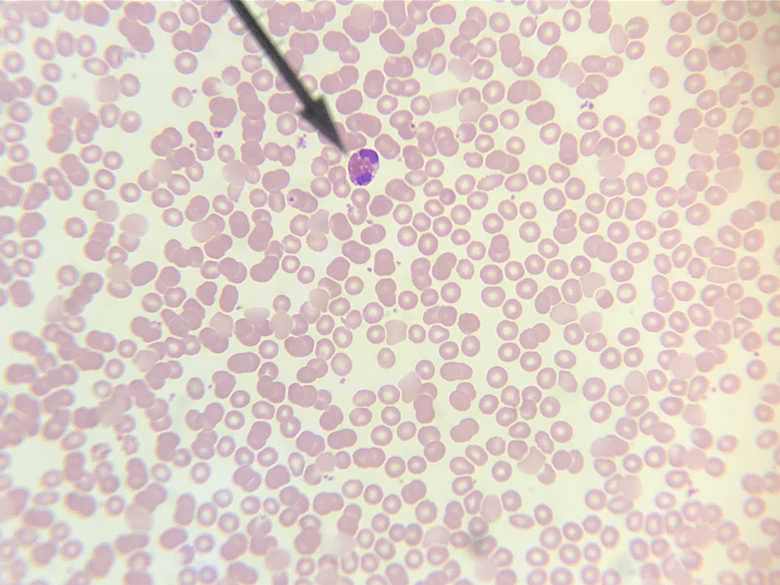
term image
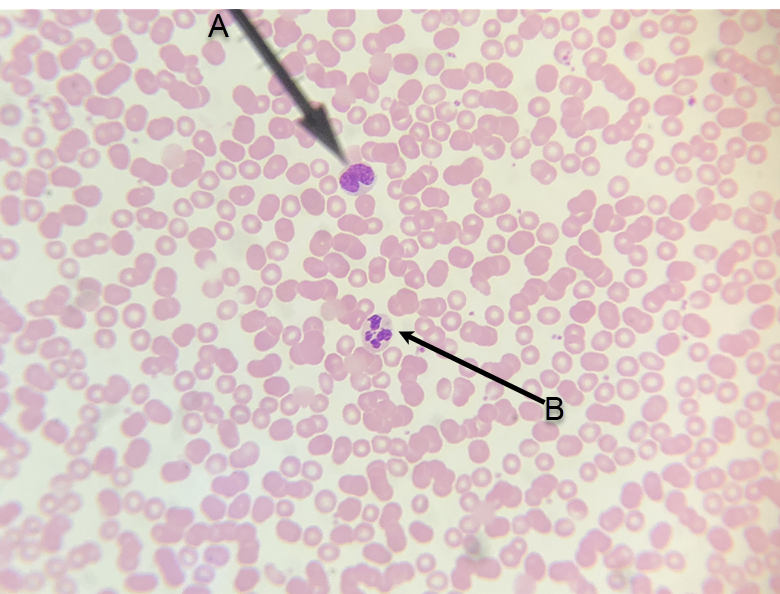
term image
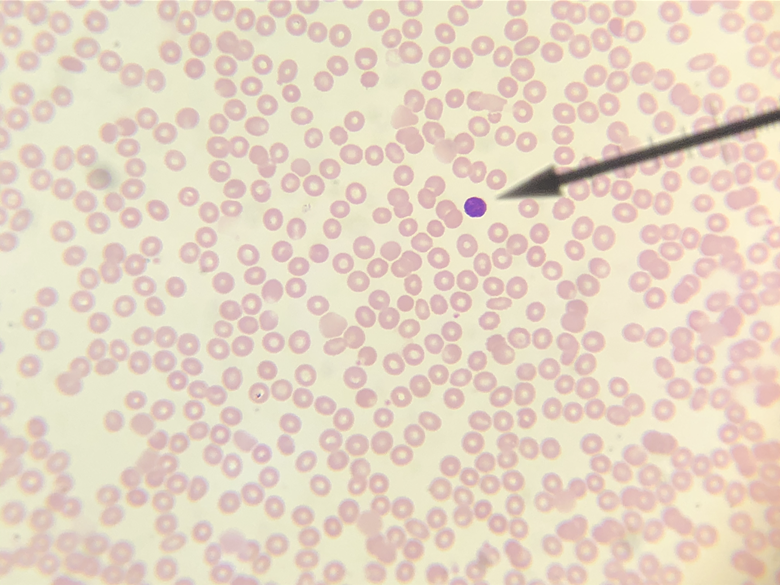
term image
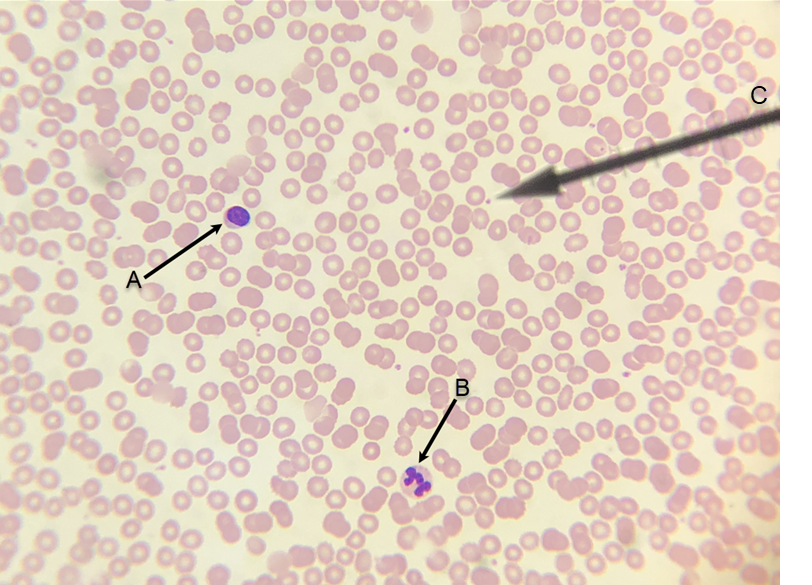
term image
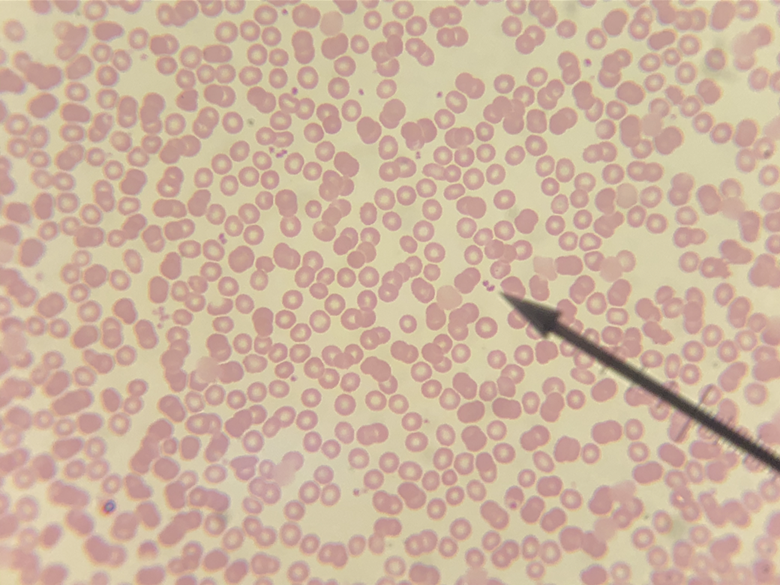
term image

1/47
Looks like no tags are added yet.
Name | Mastery | Learn | Test | Matching | Spaced | Call with Kai |
|---|
No analytics yet
Send a link to your students to track their progress
red blood cell

A. monocyte, B. neutrophil, C. monocyte or neutrophil?

lymphocyte
monocyte
eosinophil
A. monocyte, B. neutrophil

eosinophil
basophil
A. lymphocyte, B. neutrophil, C. platelet

A. red blood cell, B. neutrophils, C. platelets
platelets

A. arteries, B. vein

A. artery, B. veins

A. arteries, B. vein, C. tunica externa, D. tunica media, E. tunica intima

A. tunica intima, B. tunica media, C. tunica externa

A. tunica externa, B. venous valve

A. anterior interventricular sulcus; B. coronary a., C. coronary v.

A. anterior interventricular sulcus; B. coronary a., C. coronary v.

A. posterior interventricular sulcus; B. coronary v., C. coronary sinus, D. coronary a., E. pulmonary v., F. inferior vena cava, G. pulmonary a., H. superior vena cava, J. aorta

A. posterior interventricular sulcus; B. coronary v., C. coronary sinus, D. coronary a., E. pulmonary v., F. inferior vena cava, G. pulmonary a., H. superior vena cava, J. aorta

A. superior vena cava, B. aorta, C. pulmonary trunk, D. pulmonary a., E. pulmonary v.

A. superior vena cava, B. aorta, C. pulmonary trunk, D. pulmonary a., E. pulmonary v.

A. right atrium, B. left atrium, C. right ventricle, D. left ventricle; E. superior vena cava, F. aorta, G. pulmonary trunk; H. right AV valve, J. left AV valve, K. pulmonary valve, L. chordae tendineae, M. papillary muscle, N. interventricular septum; O. myocardium, P. endocardium, Q. epicardium

A. right atrium, B. left atrium, C. right ventricle, D. left ventricle; E. superior vena cava, F. aorta, G. pulmonary trunk; H. right AV valve, J. left AV valve, K. pulmonary valve, L. chordae tendineae, M. papillary muscle, N. interventricular septum; O. myocardium, P. endocardium, Q. epicardium

A. superior vena cava, B. inferior vena cava, C. aorta, D. pulmonary trunk; E. fossa ovalis, F. right AV valve, G. pulmonary valve, H. chordae tendineae, J. papillary muscle; K. right atrium, L. right ventricle

A. superior vena cava, B. inferior vena cava, C. aorta, D. pulmonary trunk; E. fossa ovalis, F. right AV valve, G. pulmonary valve, H. chordae tendineae, J. papillary muscle; K. right atrium, L. right ventricle

A. aorta, B. pulmonary trunk, C. pulmonary v.; D. aortic valve, E. left AV valve, F. chordae tendineae, G. papillary muscle; H. left atrium, J. left ventricle

A. aorta, B. pulmonary trunk, C. pulmonary v.; D. aortic valve, E. left AV valve, F. chordae tendineae, G. papillary muscle; H. left atrium, J. left ventricle

A. pectinate muscles, B. trabeculae carneae, C. papillary muscles; D. myocardium, E. endocardium, F. epicardium

A. pectinate muscles, B. trabeculae carneae, C. papillary muscles; D. myocardium, E. endocardium, F. epicardium
Blood Function
Neutrophils function
Eosinophils fucntion
Basophils function
Promote inflammation
Lymphocytes function
Monocytes function
Platelets function
Release clotting chemicals
Artery function
Vein fucntion
Endocardium function
Myocardium function
Right atrium function
Left atrium function
right ventricle function
Left ventricle function
Chordae tendineae function
Papillary muscles function